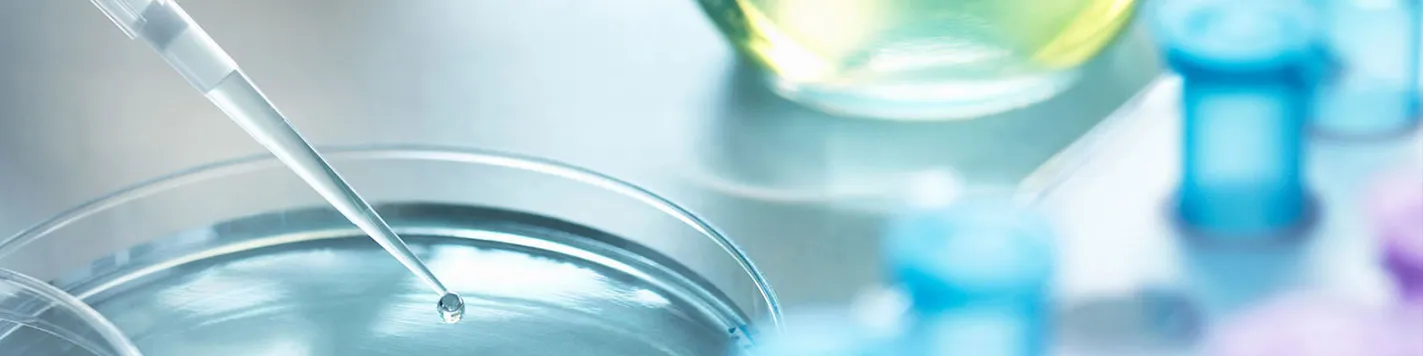

濮阳中天生物科技有限公司
濮阳中天生物科技有限公司
主营产品:
2,2,2-三氯乙酰胺
认证的制造型企业
企业类型
生产型工厂
员工总数
50人以下
成立年限
6+
注册资本
3000 万
关于我们
濮阳中天生物科技有限公司
濮阳中天生物科技有限公司,成立于2018-09-21,注册资本为3000万人民币,法定代表人为张栋明,经营状态为存续,工商注册号为410928000077420,注册地址为河南省濮阳市濮阳县濮阳市化工产业集聚区黄河路与发展路交叉口88号,经营范围包括筹建:双乙烯酮、乙酰乙酸甲酯、乙酰乙酸乙酯、脱氢乙酸、脱氢乙酸钠、丙酸钙、双乙酸钠、无水乙酸钠的生产加工、销售。
查看详情

公司介绍
最近的出口港
青岛港
最近国际机场
郑州新郑国际机场
最近的核心城市
北京
离核心城市距离
475KM